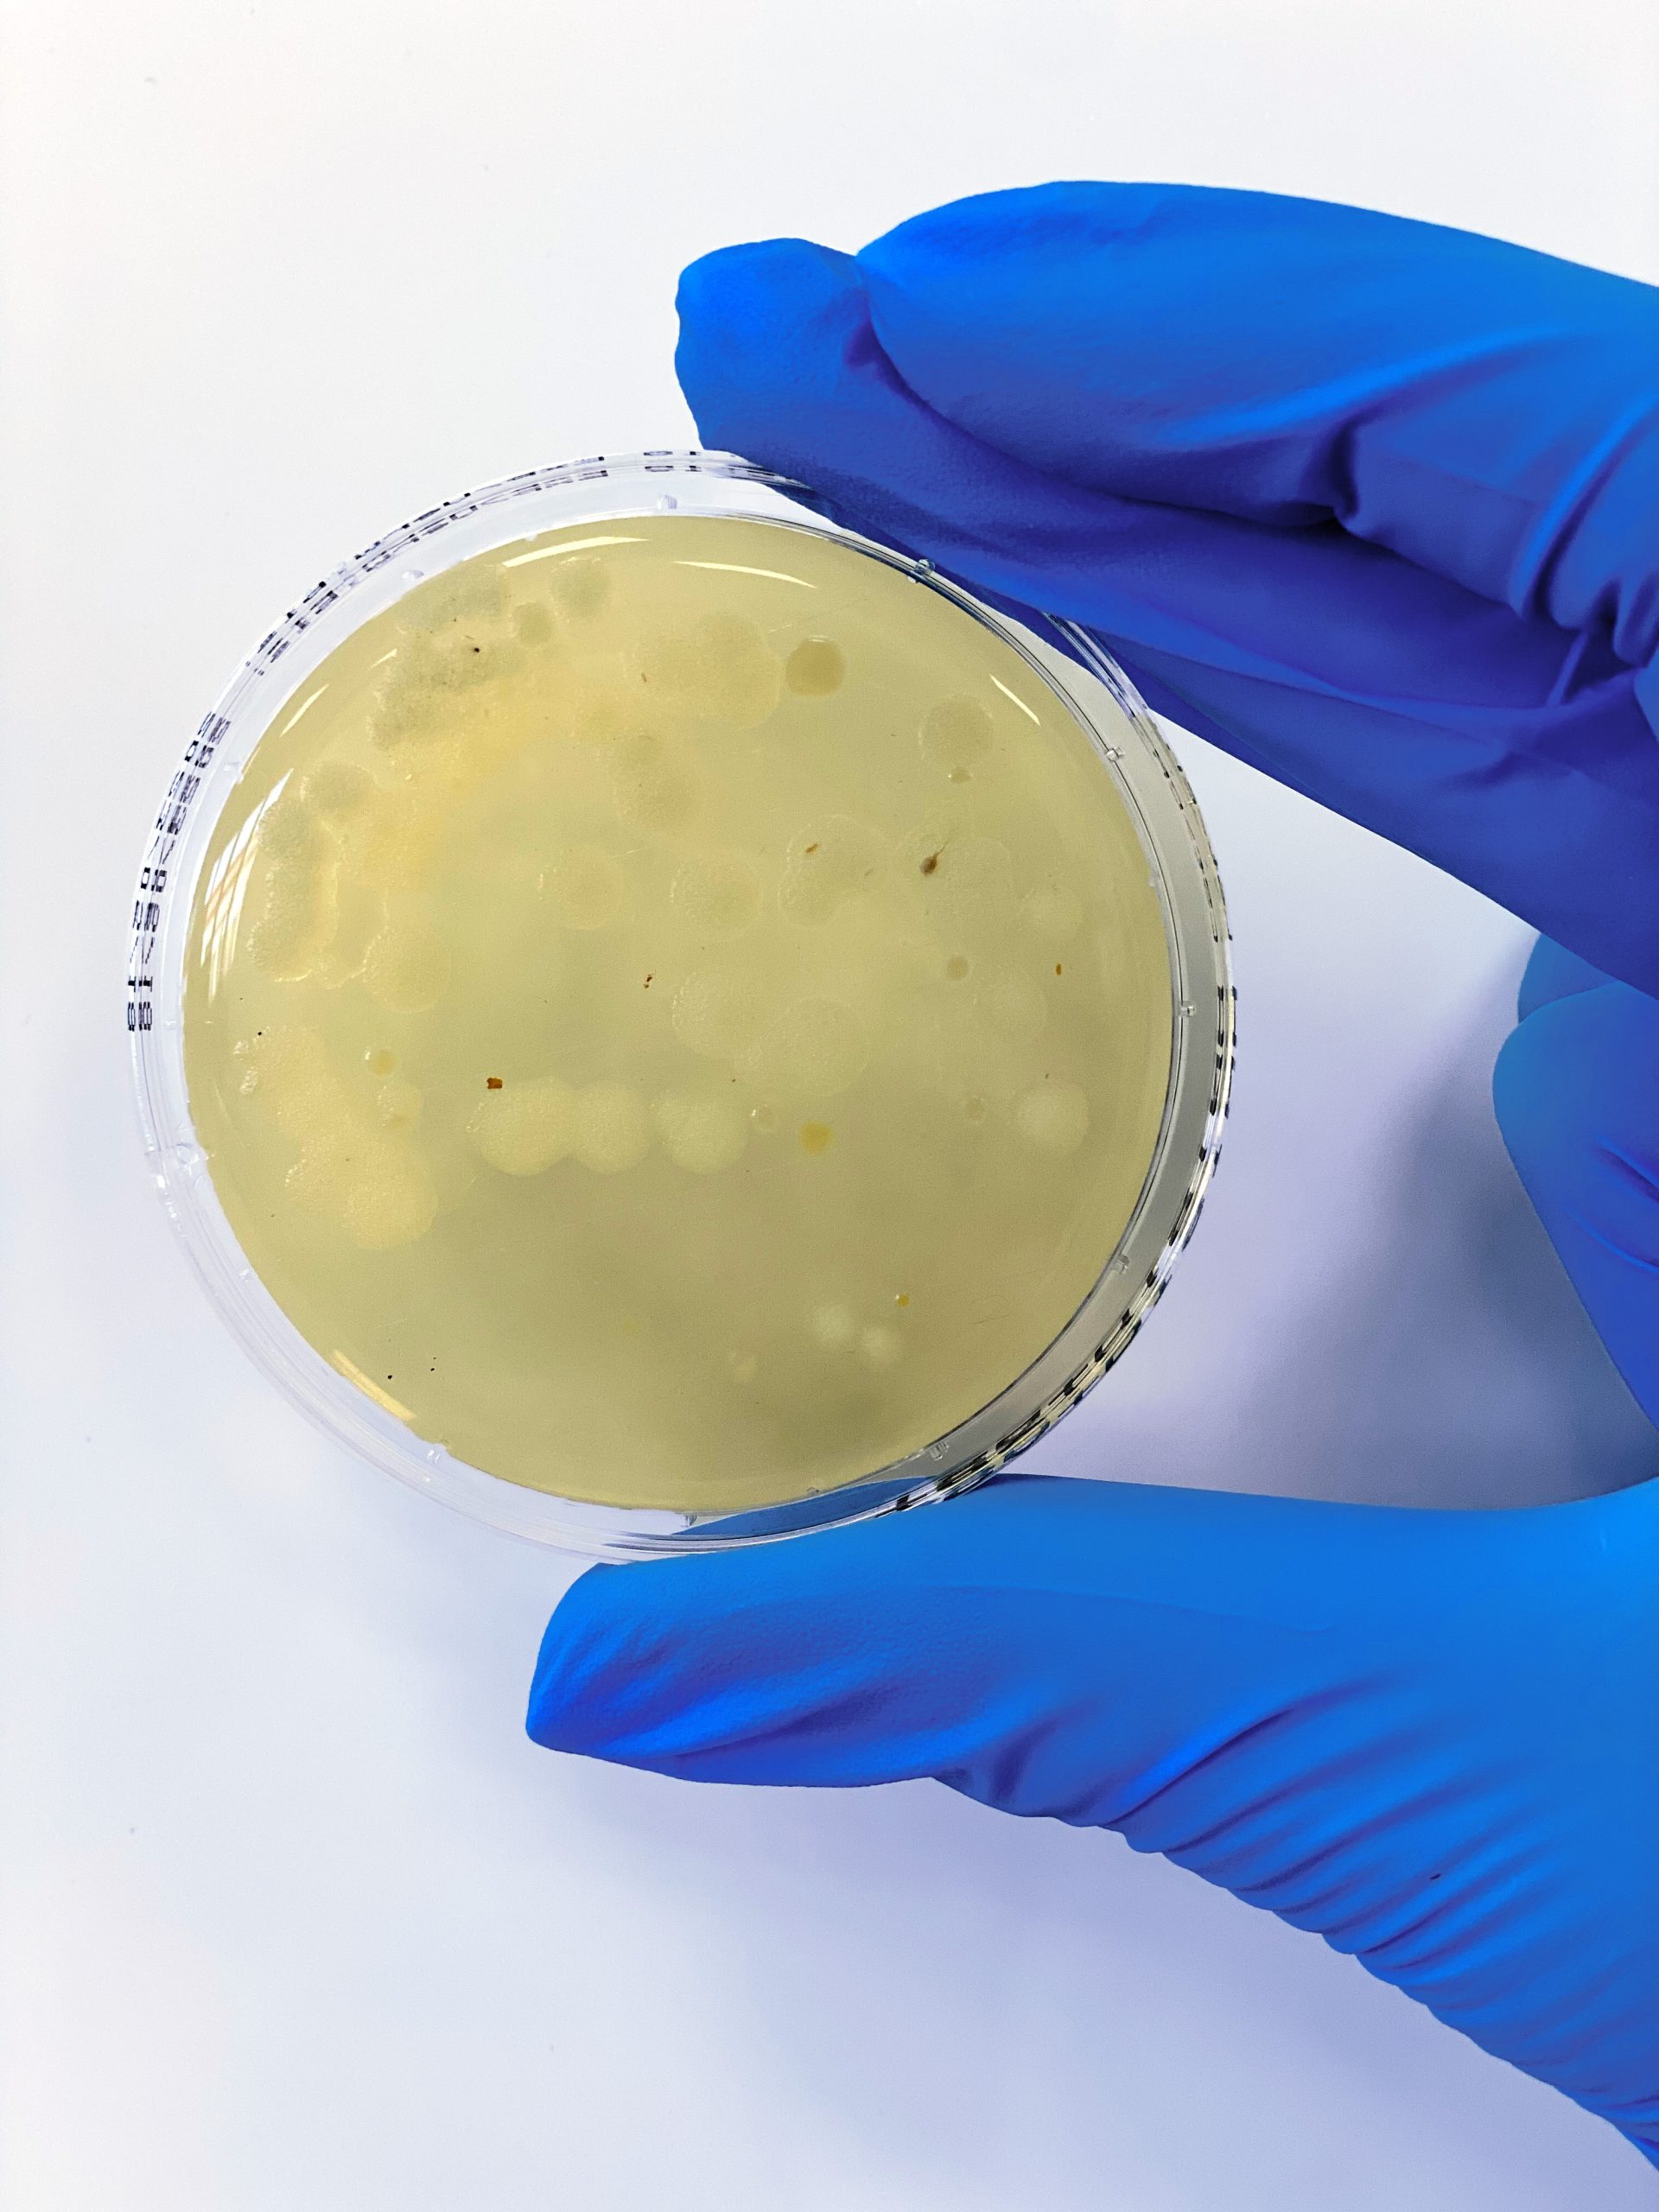

Schön, dass Sie hier sind!
Die Arbeit von Tiermedizinischen Fachangestellten ist weit mehr als Assistenz. Sie bedeutet Organisation, Verantwortung, Fachkompetenz – und ist häufig das Herz einer tierärztlichen Praxis.
Als Team von LABOKLIN wissen wir, wie entscheidend gut ausgebildete, selbstbewusste und fachlich sichere TFAs für den Praxisalltag und den Erfolg eines Teams sind. Deshalb engagieren wir uns mit Überzeugung für eine starke, hochwertige und zukunftsorientierte Aus- und Weiterbildung in diesem Beruf.
Durch langjährige Erfahrungen in verschiedenen Bereichen der Tiermedizin sowie in Ausbildung und Prüfung kennen wir die Anforderungen des Praxisalltags aus unterschiedlichen Perspektiven. Dieses Wissen fließt in unser Engagement für die Weiterentwicklung und Sicherung hoher Ausbildungsstandards ein.
Mit der TFA-Akademie von LABOKLIN möchten wir Fortbildung praxisnah, verständlich und direkt im Alltag anwendbar gestalten. Unser Ziel ist es, Sie nicht nur mit neuem Wissen zu unterstützen, sondern Ihnen auch Sicherheit für Ihren Praxisalltag, für Ihr Team und für Ihre persönliche berufliche Entwicklung zu geben.
Eine starke Tiermedizin braucht starke TFAs.
Gute Aus- und Weiterbildung schafft Selbstvertrauen.
Klare Standards schaffen Qualität.
Wertschätzung schafft Motivation.
Ihr LABOKLIN-Team

Jetzt hoch hinaus mit unserem Fortbildungs-Highlight für TFAs im Europapark am 13.06.26
Zellen sehen, Blut verstehen – Wissen mit Adrenalinkick!
Sie wollen mehr als Theorie? Dann sind Sie bei uns genau richtig! Gemeinsam tauchen wir in die praktische Zytologie ein: Wir analysieren Proben aus dem Ohr, beurteilen Leukozyten und Thrombozyten im Blutausstrich und besprechen reale Fallbeispiele direkt am Live-Mikroskop.
Schritt für Schritt, im Team und interaktiv. Die perfekte Gelegenheit, Routine zu gewinnen, Fragen zu stellen und praktische Sicherheit zu gewinnen.
Und weil Lernen auch Spaß machen darf: Nach dem gemeinsamen Mittagessen geht’s weiter in den Europa-Park – Eintritt inklusive.
Machen Sie aus Theorie praktische Erfahrung – wir freuen uns auf Sie!
WhatsApp-Kanal
Sie wollen keine Informationen mehr zu unseren TFA-Veranstaltungen verpassen? Hier informieren wir Sie immer bequem, direkt und anonym über unser Angebot per WhatsApp! Hier entlang oder einfach den QR-Code scannen:
Immer aktuell bleiben mit dem Laboklin-Newsletter
Sie wollen die neuesten Informationen aus der Wissenschaft und aktuelle Fortbildungen? Ganz einfach beim Laboklin Newsletter anmelden und keine Veranstaltung und wissenswerte News mehr verpassen!
Sicherheit beginnt mit Wissen – werden Sie Hygienebeauftragter in der Tierarztpraxis!
Hygiene ist mehr als Routine, sie schützt Ihr Team, Ihre Patienten und Ihre Praxis.
Dieser umfassende Lehrgang vermittelt praxisnahes und aktuelles Wissen rund um Hygiene, Arbeitsschutz und Infektionsprävention in der tierärztlichen Praxis.
In drei abwechslungsreichen Web-Seminaren und einer praxisorientierten Präsenzveranstaltung erhalten Sie fundiertes Fachwissen von erfahrenen Referenten.
In diesem intensiven Lehrgang lernen Sie, wie moderne Hygienekonzepte sicher geplant, dokumentiert und im Alltag umgesetzt werden.
Praxisnah. Verständlich. Sofort umsetzbar.
Sie erhalten nicht nur eine Theorie, sondern konkrete Lösungen für Ihren Praxisalltag.
Profitieren Sie vom Austausch mit Kollegen und einem exklusiven Rahmenprogramm im Get-together und gemeinsamer Abendveranstaltung.
Kontakte knüpfen. Wissen vertiefen. Sicherheit gewinnen.
→ Ist 2027 wieder verfügbar! Falls Sie Interesse haben, schreiben Sie uns eine Mail und wir setzen Sie auf die Warteliste.
TFA-Laborkurs
Die praktische Abschlussprüfung bereitet Ihnen schlaflose Nächte? Sie hatten noch keine Möglichkeit zu sehen, wie eine Flotation funktioniert? Harnsediment hatten Sie nur in der Theorie und Blutausstriche funktionieren sowieso nicht, wie sie sollen?
Keine Sorge! Sie packen das! In unserem Laborkurs haben Sie eine Woche lang Zeit, sich alle praktischen Laboraufgaben wann und so oft man will online als einzelne Tutorials anzusehen. Wir zeigen Ihnen dann live die wichtigsten Tests und nehmen uns Zeit für Ihre Fragen. Im Anschluss werden wir eine praktische Labor-Prüfung nachstellen!
Sarstedt-Infomaterial zu „Tipps & Tricks in der Präanalytik“
TFA-Mappe Präanalytik
Blut, Urin, Kot – richtig gemacht von Anfang an: Die LABOKLIN x SARSTEDT-Mappe „Tipps & Tricks in der Präanalytik“ zeigt kompakt, worauf es bei Entnahme, Röhrchen-/Gefäßwahl, Beschriftung, Lagerung und Versand ankommt – damit Ergebnisse wirklich aussagekräftig sind. Band 1 (Blut) hilft mit vielen Abbildungen, Merkkästen, Blutausstrich-Praxis und Video-Tutorials; Band 2 (Urin) und Band 3 (Kot) ergänzen das Set um klare Schritt-für-Schritt-Hilfen und typische Fehlerquellen im Praxisalltag.
Praktisch, verständlich, prüfungsrelevant – Labordiagnostik in der Tierarztpraxis
Zur Prüfungs-Vorbereitung und Absicherung im Alltag für allerlei relevante Fragen für TFA finden Sie bei Lehmanns noch einige wissenschaftliche Fachliteratur! Hier finden Sie die heißersehnte Neuauflage des hauseigenen Buches für TFA.